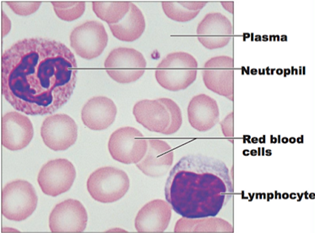
Capture.PNG

How is composition of lymph different from blood plasma?
Plasma is the matrix or the extracellular fluid of the blood tissue. It is straw colored, non living, and slightly alkaline, aqueous fluid with pH of 7.4. About 30-35% of blood is plasma.
Plasma contains: Water (About 91%), Plasma proteins (about 7%), Organic substances and inorganic substances (2%).
Lymph is an interstitial fluid, present between the cells of a tissue. Exchange of metabolites, gases and waste products takes place through the fluid.
Lymph has a composition comparable to that of blood plasma, but it may differ slightly. Lymph contains white blood cells.
